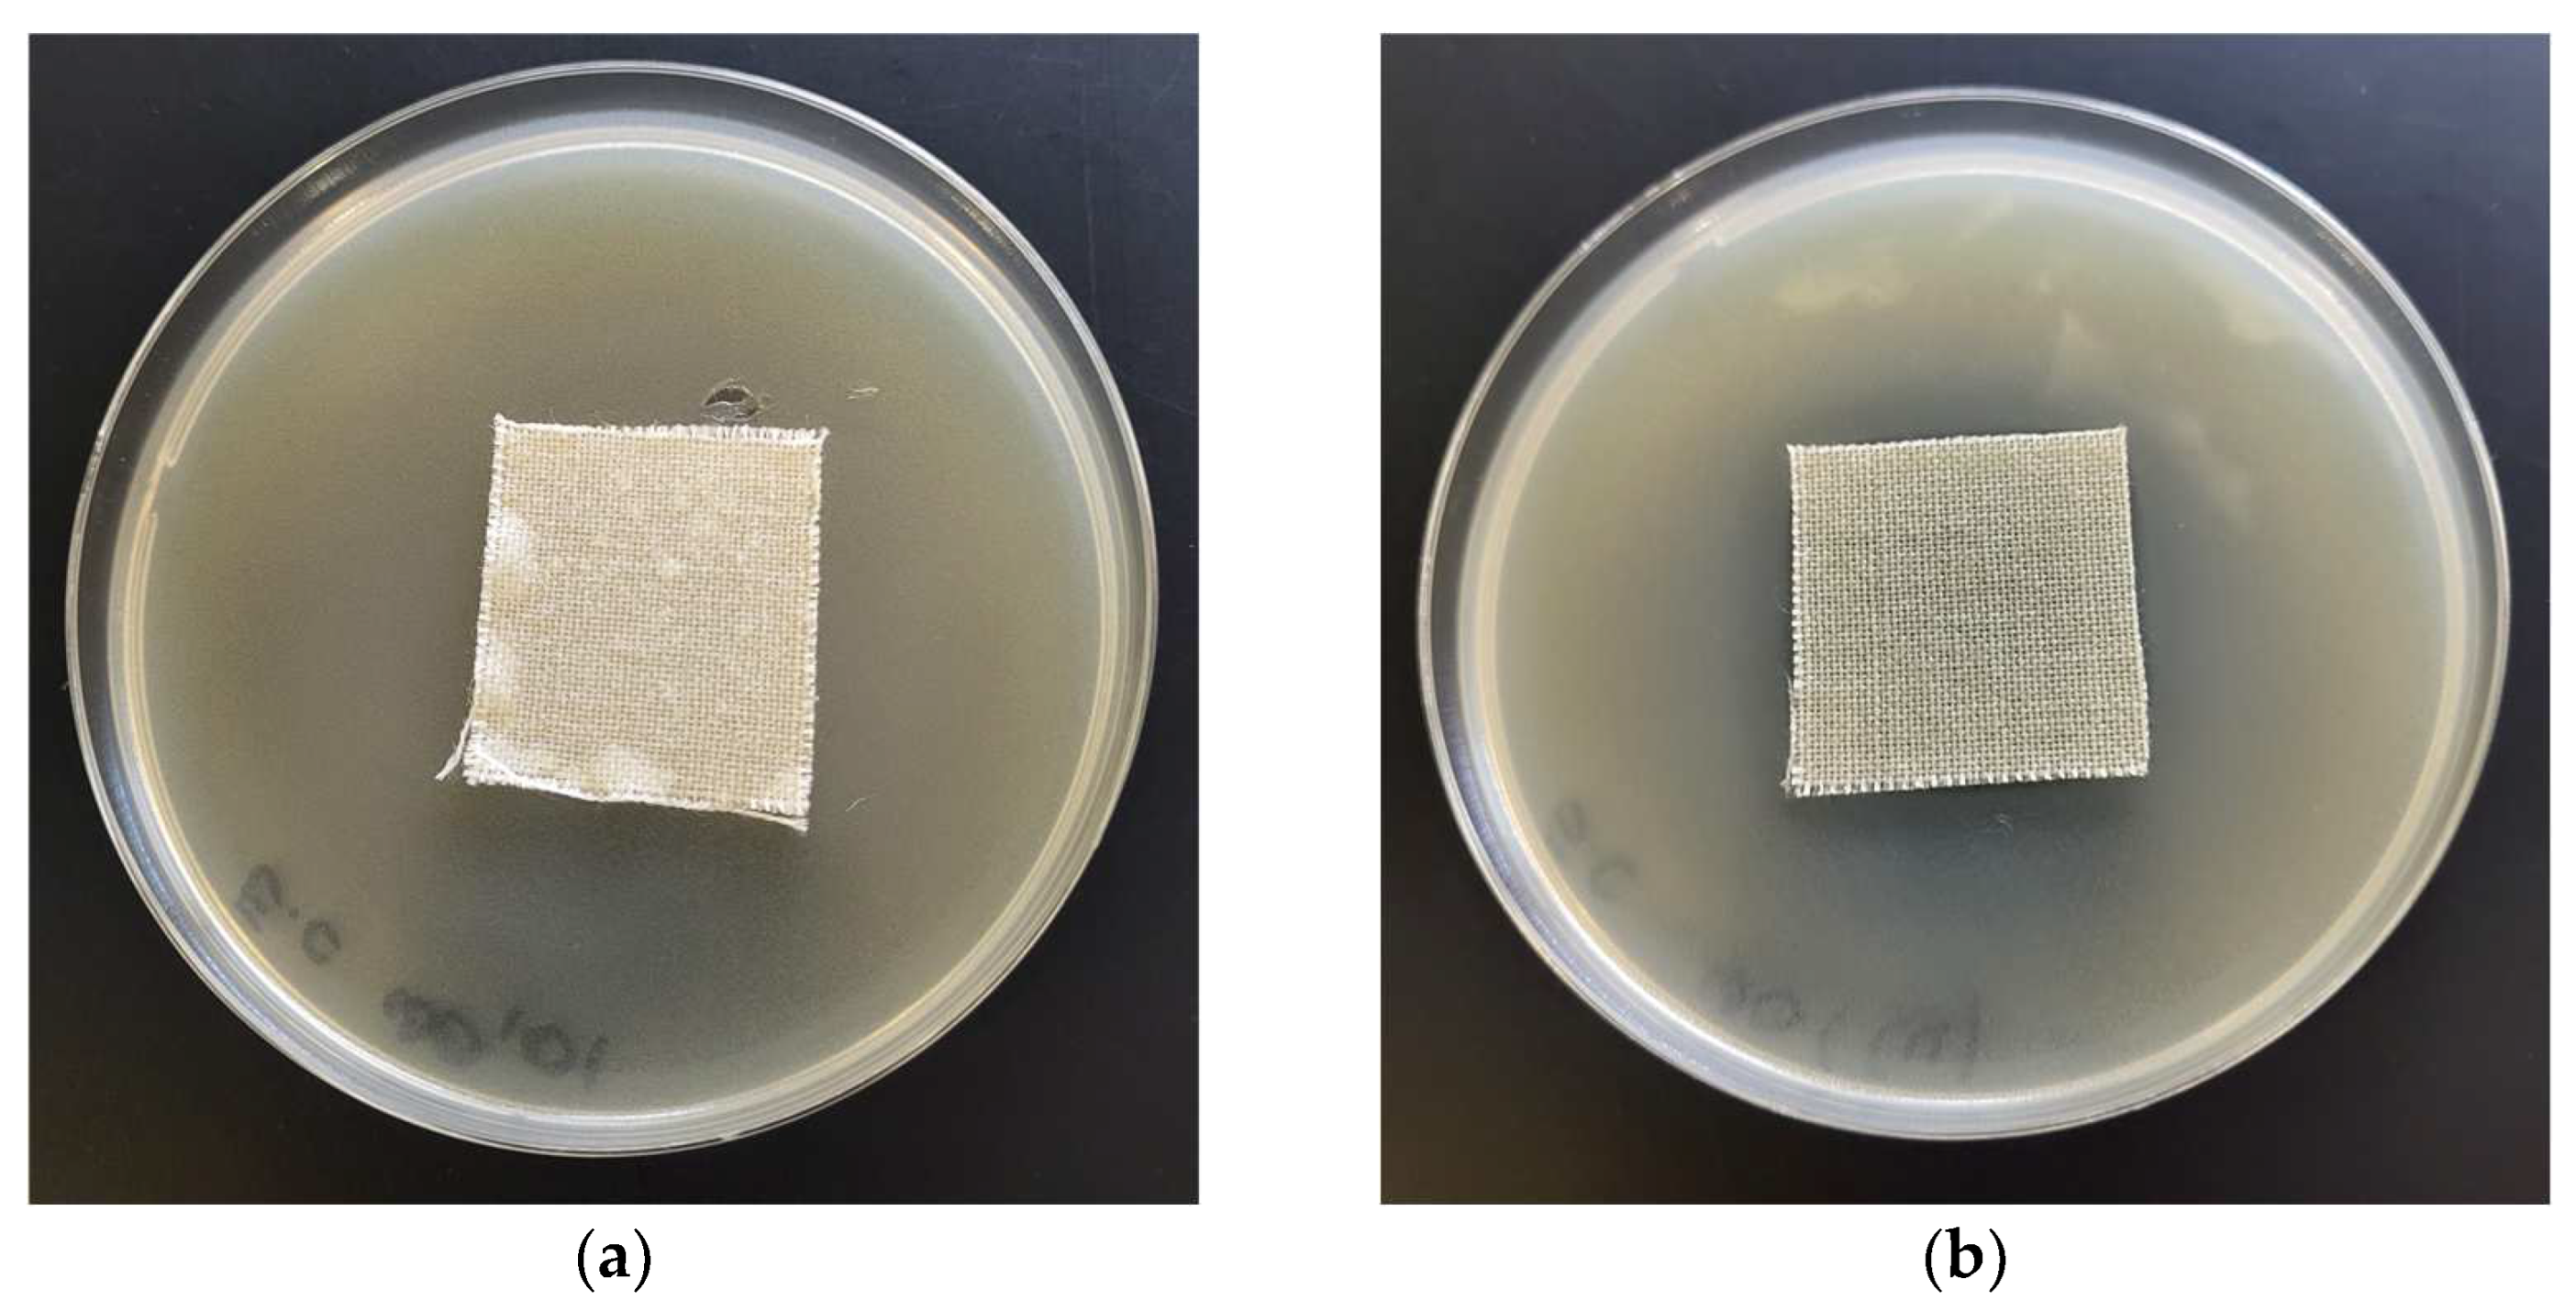
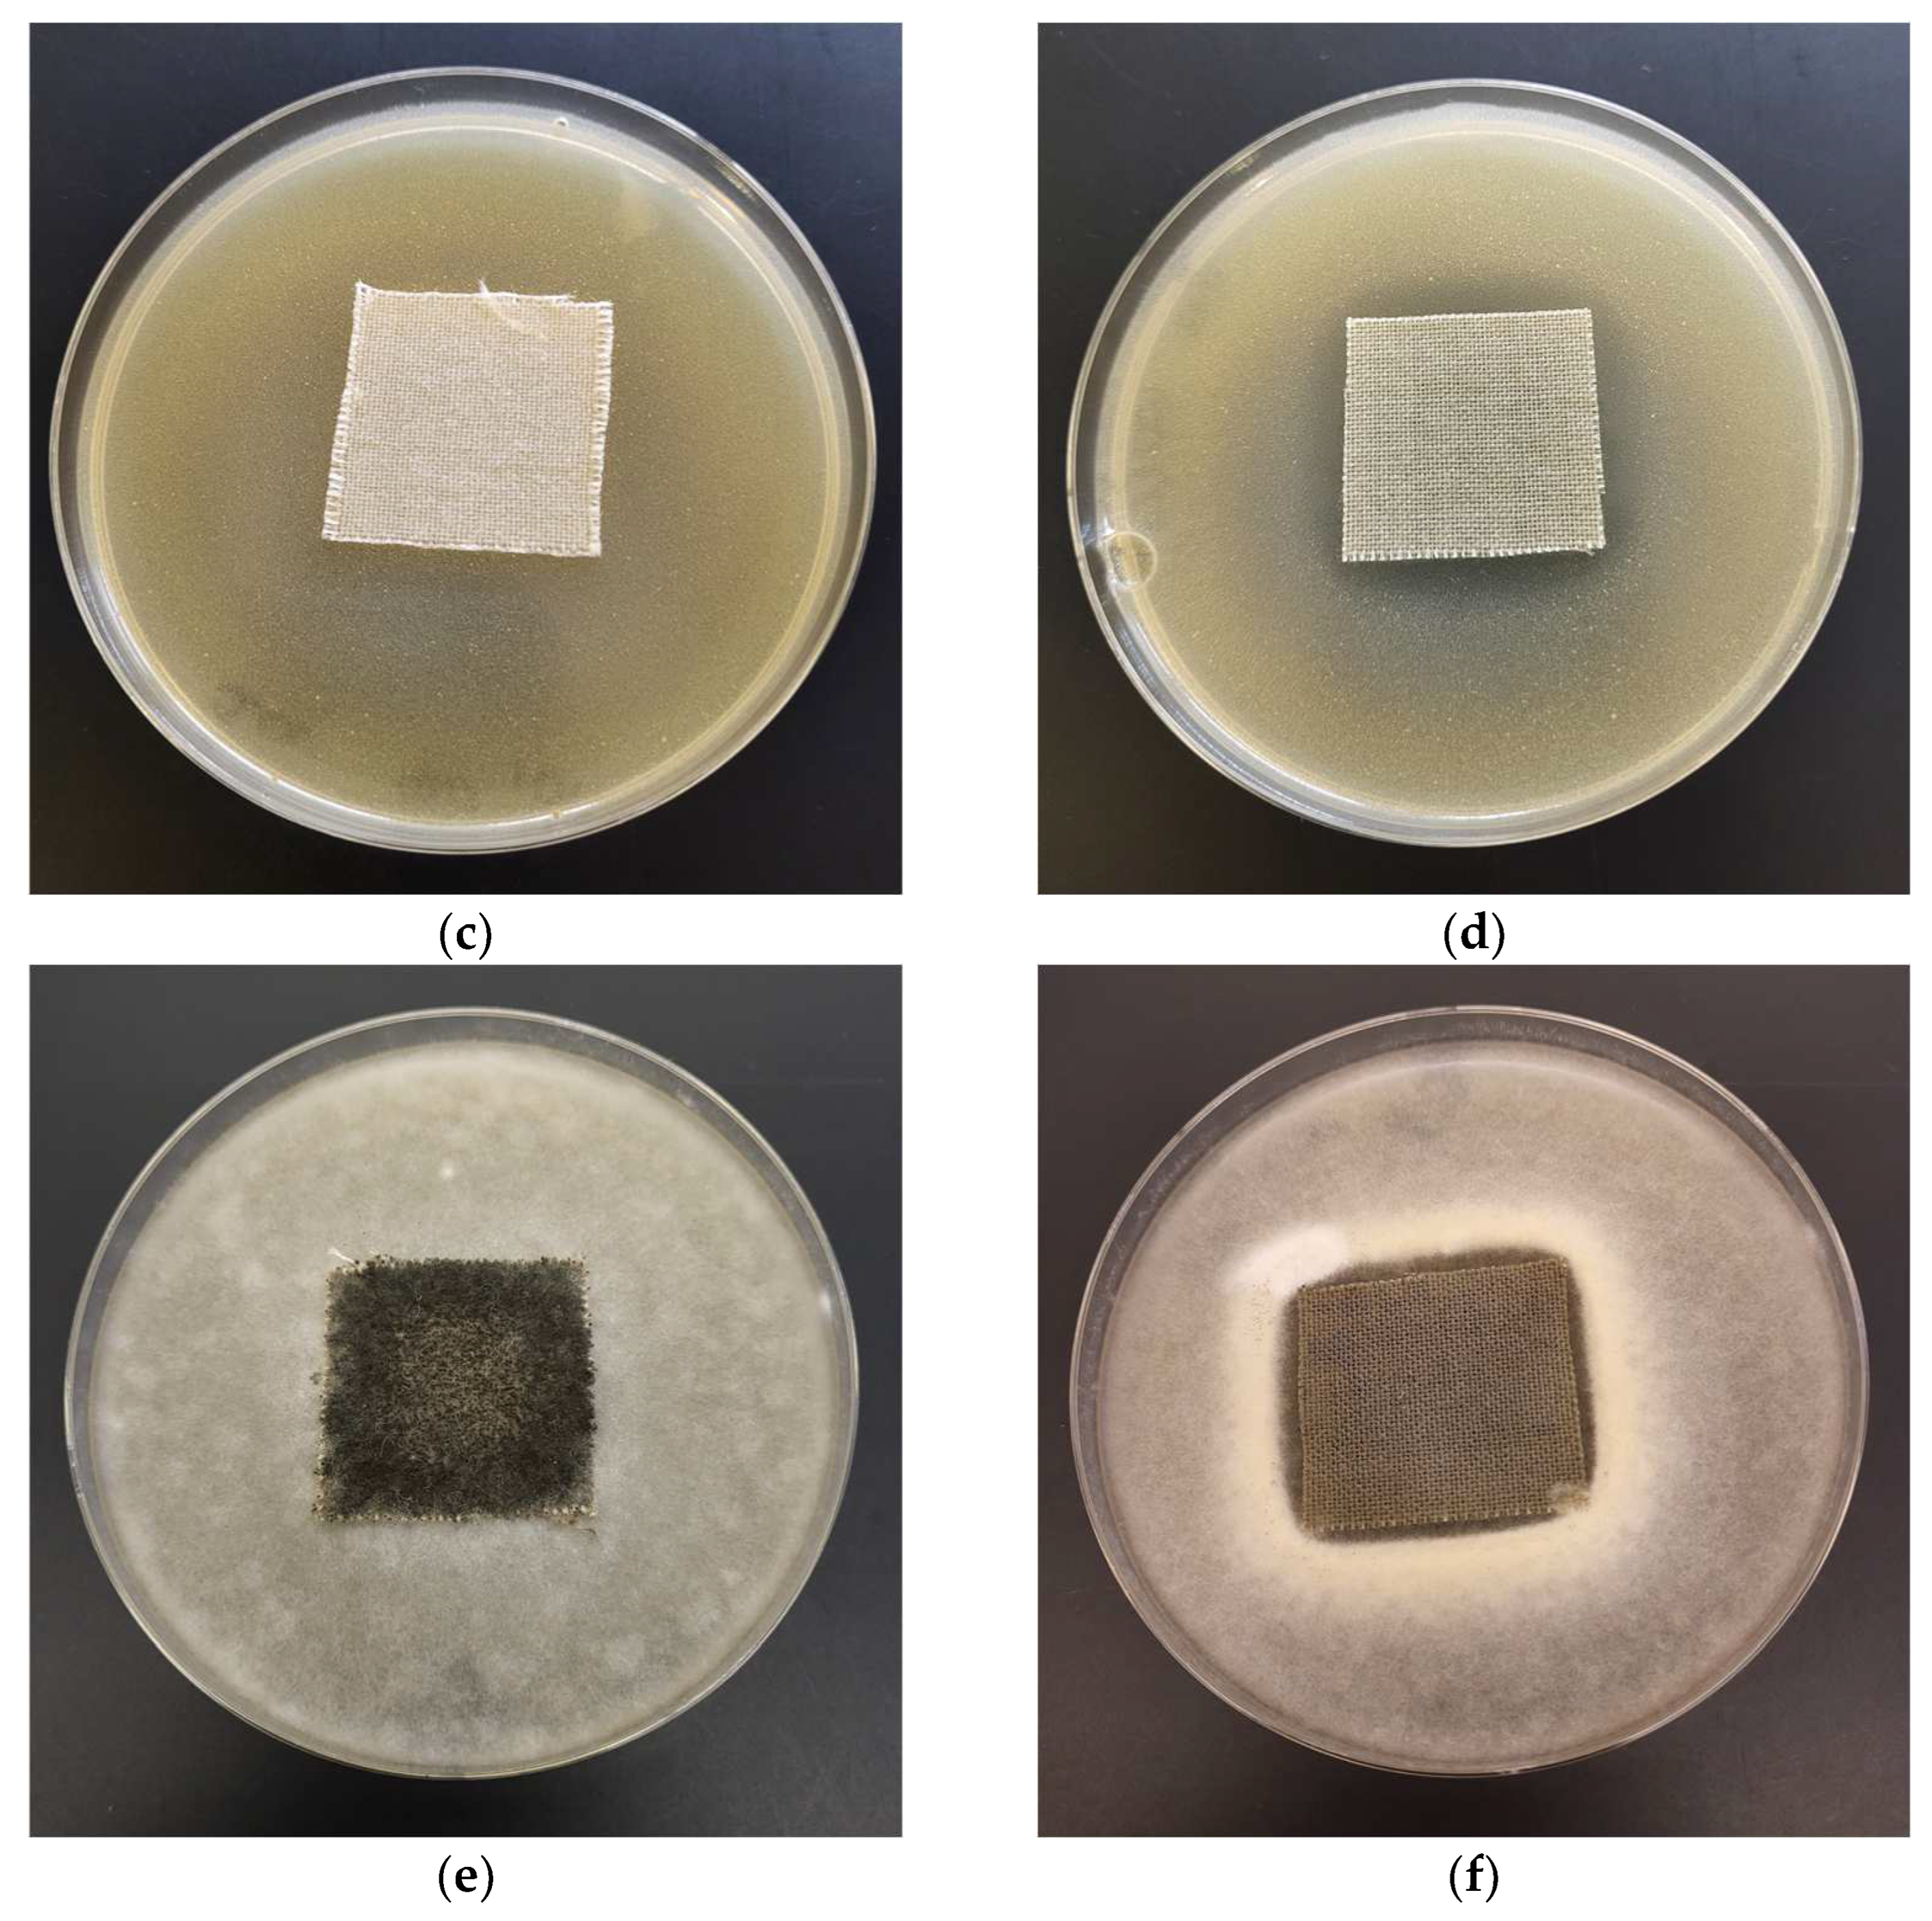

Biochemical Behavior, Influence on Cell DNA Condition, and Microbiological Properties of Wool and Wool–Copper Materials
Abstract
1. Introduction
2. Materials and Methods
2.1. Materials
2.1.1. Materials Used for Fabrication
- Copper target from Testbourne Ltd. (Basingstoke, UK) with 99.99% purity;
- Woolen-adjacent fabric, manufactured by SDL ATLAS Textile Testing Solutions (Rock Hill, SC, USA). The characteristics of the woolen-adjacent fabric are presented in Table 1.
2.1.2. Microbiological Strains Used for Antimicrobial Activity Assesment
- Escherichia coli (ATCC 25922);
- Staphylococcus aureus (ATCC 6538);
- Chaetomium globosum (ATCC 6205).
2.2. Methods
2.2.1. Magnetron Sputtering Modification
2.2.2. Wool—Copper Material Physio-Chemical Characterization
Atomic Absorption Spectrometry with Flame Excitation (FAAS)
- M—total copper content (bulk copper content) (mg/kg);
- C—metal concentration in the tested solution (mg/L);
- V—volume of the sample solution (mL);
- m—mass of the mineralized sample (g).
Microscopic Analysis
Specific Surface Area and Total Pore Volume Analysis
2.2.3. Wool–Copper Material Biological Characterization
Antimicrobial Properties
Biochemical Properties
- Plasmid relaxation assay
- 2.
- Activated Partial Thromboplastin Time (aPTT) and Pro-thrombin Time (PT)
3. Results and Discussion
3.1. Magnetron Sputtering Modification
3.2. Physico-Chemical Characteristic of WO-Cu Materials
3.2.1. Atomic Absorption Spectrometry with Flame Excitation (FAAS)
3.2.2. Microscopic Analysis
3.2.3. Specific Surface Area and Total Pore Volume Analysis
3.3. Microbiological Properties
3.4. Biochemical Properties
3.4.1. Plasmid Relaxation Assay
3.4.2. Activated Partial Thromboplastin Time (aPTT) and Pro-Thrombin Time (PTT)
4. Conclusions
- The wool samples (WO) were successful modified by the surface deposition of metallic copper using a direct current (DC) magnetron sputtering system;
- The investigated wool–copper materials have the ability to interact with bacterial DNA, resulting in breaks and changes in the conformation of the plasmid;
- The activated partial thromboplastin time (aPTT) of the modified samples (WO-Cu(t)(MBC)) was longer compared to the unmodified wool sample (WO). As the amount of the metallic copper on the wool surface increased, the aPTT also increased. No change was observed in the case of the pro-thrombin time;
- The good antimicrobial and antifungal effect of the wool–copper materials (WO-Cu(SpT)(MBC)) suggests a potential application as an antibacterial/antifungal material. Moreover, wool–copper (WO-Cu) materials may be applied as new customized materials, where the blood coagulation process could be well controlled by the copper concentration.
Supplementary Materials
Author Contributions
Funding
Institutional Review Board Statement
Informed Consent Statement
Data Availability Statement
Acknowledgments
Conflicts of Interest
References
- Boulton, A.J.; Lewis, C.T.; Naumann, D.N.; Midwinter, M.J. Prehospital Haemostatic Dressings for Trauma: A Systematic Review. Emerg. Med. J. 2018, 35, 449–457. [Google Scholar] [CrossRef]
- Mohamed, S.A.; Hargest, R. Surgical Anatomy of the Skin. Surg. Oxf. 2022, 40, 1–7. [Google Scholar] [CrossRef]
- Sorg, H.; Tilkorn, D.J.; Hager, S.; Hauser, J.; Mirastschijski, U. Skin Wound Healing: An Update on the Current Knowledge and Concepts. Eur. Surg. Res. 2017, 58, 81–94. [Google Scholar] [CrossRef] [PubMed]
- Sorg, H.; Sorg, C.G.G. Skin Wound Healing: Of Players, Patterns, and Processes. Eur. Surg. Res. 2023, 64, 141–157. [Google Scholar] [CrossRef]
- D’Alessandro, A.; Anastasiadi, A.T.; Tzounakas, V.L.; Nemkov, T.; Reisz, J.A.; Kriebardis, A.G.; Zimring, J.C.; Spitalnik, S.L.; Busch, M.P. Red Blood Cell Metabolism In Vivo and In Vitro. Metabolites 2023, 13, 793. [Google Scholar] [CrossRef] [PubMed]
- Dhivya, S.; Padma, V.V.; Santhini, E. Wound Dressings—A Review. BioMedicine 2015, 5, 22. [Google Scholar] [CrossRef]
- Rezvani Ghomi, E.; Khalili, S.; Nouri Khorasani, S.; Esmaeely Neisiany, R.; Ramakrishna, S. Wound Dressings: Current Advances and Future Directions. J. Appl. Polym. Sci. 2019, 136, 47738. [Google Scholar] [CrossRef]
- Michalicha, A.; Belcarz, A.; Giannakoudakis, D.A.; Staniszewska, M.; Barczak, M. Designing Composite Stimuli-Responsive Hydrogels for Wound Healing Applications: The State-of-the-Art and Recent Discoveries. Materials 2024, 17, 278. [Google Scholar] [CrossRef] [PubMed]
- Wang, H.; Zhang, L.-M. Intelligent Biobased Hydrogels for Diabetic Wound Healing: A Review. Chem. Eng. J. 2024, 484, 149493. [Google Scholar] [CrossRef]
- Yaron, J.R.; Gosangi, M.; Pallod, S.; Rege, K. In Situ Light-activated Materials for Skin Wound Healing and Repair: A Narrative Review. Bioeng. Transl. Med. 2024, 9, e10637. [Google Scholar] [CrossRef]
- Zheng, Q.; Chen, C.; Liu, Y.; Gao, J.; Li, L.; Yin, C.; Yuan, X. Metal Nanoparticles: Advanced and Promising Technology in Diabetic Wound Therapy. Int. J. Nanomed. 2024, 19, 965–992. [Google Scholar] [CrossRef]
- Bishop, A. Factors Influencing Dressing Choice in Wound Care: A Discussion. Br. J. Nurs. 2023, 32, S12–S20. [Google Scholar] [CrossRef] [PubMed]
- Choudhury, A.; Venkatesh, D.N.; Kumar, P.J.; Mohammed, A.P.M. Advanced Wound Care with Biopolymers. Res. J. Pharm. Technol. 2023, 16, 2522–2530. [Google Scholar] [CrossRef]
- Tran, H.Q.; Shahriar, S.M.S.; Yan, Z.; Xie, J. Recent Advances in Functional Wound Dressings. Adv. Wound Care 2023, 12, 399–427. [Google Scholar] [CrossRef]
- Vivcharenko, V.; Trzaskowska, M.; Przekora, A. Wound Dressing Modifications for Accelerated Healing of Infected Wounds. Int. J. Mol. Sci. 2023, 24, 7193. [Google Scholar] [CrossRef]
- Yousefian, F.; Hesari, R.; Jensen, T.; Obagi, S.; Rgeai, A.; Damiani, G.; Bunick, C.G.; Grada, A. Antimicrobial Wound Dressings: A Concise Review for Clinicians. Antibiotics 2023, 12, 1434. [Google Scholar] [CrossRef] [PubMed]
- Guo, B.; Dong, R.; Liang, Y.; Li, M. Haemostatic Materials for Wound Healing Applications. Nat. Rev. Chem. 2021, 5, 773–791. [Google Scholar] [CrossRef] [PubMed]
- Yu, P.; Zhong, W. Hemostatic Materials in Wound Care. Burn. Trauma 2021, 9, tkab019. [Google Scholar] [CrossRef]
- Guo, Y.; Wang, M.; Liu, Q.; Liu, G.; Wang, S.; Li, J. Recent Advances in the Medical Applications of Hemostatic Materials. Theranostics 2023, 13, 161–196. [Google Scholar] [CrossRef]
- Simões, D.; Miguel, S.P.; Ribeiro, M.P.; Coutinho, P.; Mendonça, A.G.; Correia, I.J. Recent Advances on Antimicrobial Wound Dressing: A Review. Eur. J. Pharm. Biopharm. 2018, 127, 130–141. [Google Scholar] [CrossRef]
- Nethi, S.K.; Das, S.; Patra, C.R.; Mukherjee, S. Recent Advances in Inorganic Nanomaterials for Wound-Healing Applications. Biomater. Sci. 2019, 7, 2652–2674. [Google Scholar] [CrossRef] [PubMed]
- Ijaola, A.O.; Akamo, D.O.; Damiri, F.; Akisin, C.J.; Bamidele, E.A.; Ajiboye, E.G.; Berrada, M.; Onyenokwe, V.O.; Yang, S.-Y.; Asmatulu, E. Polymeric Biomaterials for Wound Healing Applications: A Comprehensive Review. J. Biomater. Sci. Polym. Ed. 2022, 33, 1998–2050. [Google Scholar] [CrossRef] [PubMed]
- Mirhaj, M.; Labbaf, S.; Tavakoli, M.; Seifalian, A. An Overview on the Recent Advances in the Treatment of Infected Wounds: Antibacterial Wound Dressings. Macromol. Biosci. 2022, 22, 2200014. [Google Scholar] [CrossRef] [PubMed]
- Lu, Z.; Yu, D.; Nie, F.; Wang, Y.; Chong, Y. Iron Nanoparticles Open Up New Directions for Promoting Healing in Chronic Wounds in the Context of Bacterial Infection. Pharmaceutics 2023, 15, 2327. [Google Scholar] [CrossRef] [PubMed]
- Prete, S.; Dattilo, M.; Patitucci, F.; Pezzi, G.; Parisi, O.I.; Puoci, F. Natural and Synthetic Polymeric Biomaterials for Application in Wound Management. J. Funct. Biomater. 2023, 14, 455. [Google Scholar] [CrossRef] [PubMed]
- Verma, D.; Okhawilai, M.; Nangan, S.; Thakur, V.K.; Gopi, S.; Kuppusamy, K.; Sharma, M.; Uyama, H. A Sustainable and Green Approach towards the Utilization of Biopolymers for Effective Wound Dressing Applications: A Detailed Review. Nano-Struct. Nano-Objects 2024, 37, 101086. [Google Scholar] [CrossRef]
- Kudzin, M.H.; Kaczmarek, A.; Mrozińska, Z.; Olczyk, J. Deposition of Copper on Polyester Knitwear Fibers by a Magnetron Sputtering System. Physical Properties and Evaluation of Antimicrobial Response of New Multi-Functional Composite Materials. Appl. Sci. 2020, 10, 6990. [Google Scholar] [CrossRef]
- Kudzin, M.H.; Mrozińska, Z.; Kaczmarek, A.; Lisiak-Kucińska, A. Deposition of Copper on Poly(Lactide) Non-Woven Fabrics by Magnetron Sputtering—Fabrication of New Multi-Functional, Antimicrobial Composite Materials. Materials 2020, 13, 3971. [Google Scholar] [CrossRef] [PubMed]
- Kudzin, M.H.; Boguń, M.; Mrozińska, Z.; Kaczmarek, A. Physical Properties, Chemical Analysis, and Evaluation of Antimicrobial Response of New Polylactide/Alginate/Copper Composite Materials. Mar. Drugs 2020, 18, 660. [Google Scholar] [CrossRef]
- Kudzin, M.H.; Giełdowska, M.; Mrozińska, Z.; Boguń, M. Poly(Lactic Acid)/Zinc/Alginate Complex Material: Preparation and Antimicrobial Properties. Antibiot. Basel Switz. 2021, 10, 1327. [Google Scholar] [CrossRef]
- Mrozińska, Z.; Ponczek, M.; Kaczmarek, A.; Boguń, M.; Sulak, E.; Kudzin, M.H. Blood Coagulation Activities of Cotton–Alginate–Copper WO-Cu materials. Mar. Drugs 2023, 21, 625. [Google Scholar] [CrossRef]
- Mrozińska, Z.; Kudzin, M.H.; Ponczek, M.B.; Kaczmarek, A.; Król, P.; Lisiak-Kucińska, A.; Żyłła, R.; Walawska, A. Biochemical Approach to Poly(Lactide)–Copper Composite—Impact on Blood Coagulation Processes. Materials 2024, 17, 608. [Google Scholar] [CrossRef]
- Konop, M.; Rybka, M.; Drapała, A. Keratin Biomaterials in Skin Wound Healing, an Old Player in Modern Medicine: A Mini Review. Pharmaceutics 2021, 13, 2029. [Google Scholar] [CrossRef] [PubMed]
- Ranjit, E.; Hamlet, S.; George, R.; Sharma, A.; Love, R.M. Biofunctional Approaches of Wool-Based Keratin for Tissue Engineering. J. Sci. Adv. Mater. Devices 2022, 7, 100398. [Google Scholar] [CrossRef]
- Ye, W.; Qin, M.; Qiu, R.; Li, J. Keratin-Based Wound Dressings: From Waste to Wealth. Int. J. Biol. Macromol. 2022, 211, 183–197. [Google Scholar] [CrossRef] [PubMed]
- Durrant, P.J.; Durrant, B. Introduction to Advanced Inorganic Chemistry; Longmans, Green & Co.: London, UK, 1962. [Google Scholar]
- Bertocci, U.; Wagman, D.D. Copper, silver and gold. In Standard Potentials in Aqueous Solution, 1st ed.; Bard, A.J., Parsons, R., Jordan, J., Eds.; Marcel Dekker, Inc.: New York, NY, USA, 1985; pp. 287–294. ISBN 978-0-203-73876-4. [Google Scholar]
- Allen, S.E.; Walvoord, R.R.; Padilla-Salinas, R.; Kozlowski, M.C. Aerobic Copper-Catalyzed Organic Reactions. Chem. Rev. 2013, 113, 6234–6458. [Google Scholar] [CrossRef]
- De Sousa, P.V.F.; De Oliveira, A.F.; Da Silva, A.A.; Lopes, R.P. Environmental Remediation Processes by Zero Valence Copper: Reaction Mechanisms. Environ. Sci. Pollut. Res. 2019, 26, 14883–14903. [Google Scholar] [CrossRef] [PubMed]
- Zerk, T.J.; Bernhardt, P.V. Redox-Coupled Structural Changes in Copper Chemistry: Implications for Atom Transfer Catalysis. Coord. Chem. Rev. 2018, 375, 173–190. [Google Scholar] [CrossRef]
- Borkow, G.; Gabbay, J. Copper as a Biocidal Tool. Curr. Med. Chem. 2005, 12, 2163–2175. [Google Scholar] [CrossRef]
- Borkow, G.; Gabbay, J. Copper, An Ancient Remedy Returning to Fight Microbial, Fungal and Viral Infections. Curr. Chem. Biol. 2009, 3, 272–278. [Google Scholar] [CrossRef]
- Grass, G.; Rensing, C.; Solioz, M. Metallic Copper as an Antimicrobial Surface. Appl. Environ. Microbiol. 2011, 77, 1541–1547. [Google Scholar] [CrossRef] [PubMed]
- Chyderiotis, S.; Legeay, C.; Verjat-Trannoy, D.; Le Gallou, F.; Astagneau, P.; Lepelletier, D. Efficacy of Copper Surfaces in the Healthcare Environment: A Systematic Review. Antimicrob. Resist. Infect. Control 2015, 4, P45. [Google Scholar] [CrossRef]
- Vincent, M.; Duval, R.E.; Hartemann, P.; Engels-Deutsch, M. Contact Killing and Antimicrobial Properties of Copper. J. Appl. Microbiol. 2018, 124, 1032–1046. [Google Scholar] [CrossRef] [PubMed]
- Ermini, M.L.; Voliani, V. Antimicrobial Nano-Agents: The Copper Age. ACS Nano 2021, 15, 6008–6029. [Google Scholar] [CrossRef]
- Crisan, M.C.; Teodora, M.; Lucian, M. Copper Nanoparticles: Synthesis and Characterization, Physiology, Toxicity and Antimicrobial Applications. Appl. Sci. 2021, 12, 141. [Google Scholar] [CrossRef]
- Maliki, M.; Ifijen, I.H.; Ikhuoria, E.U.; Jonathan, E.M.; Onaiwu, G.E.; Archibong, U.D.; Ighodaro, A. Copper Nanoparticles and Their Oxides: Optical, Anticancer and Antibacterial Properties. Int. Nano Lett. 2022, 12, 379–398. [Google Scholar] [CrossRef]
- Li, X.; Cong, Y.; Ovais, M.; Cardoso, M.B.; Hameed, S.; Chen, R.; Chen, M.; Wang, L. Copper-based Nanoparticles against Microbial Infections. WIREs Nanomed. Nanobiotechnol. 2023, 15, e1888. [Google Scholar] [CrossRef] [PubMed]
- Yimeng, S.; Huilun, X.; Ziming, L.; Kejun, L.; Chaima, M.; Xiangyu, Z.; Yinchun, H.; Yan, W.; Di, H. Copper-Based Nanoparticles as Antibacterial Agents. Eur. J. Inorg. Chem. 2023, 26, e202200614. [Google Scholar] [CrossRef]
- Cortes, A.A.; Zuñiga, J.M. The Use of Copper to Help Prevent Transmission of SARS-Coronavirus and Influenza Viruses. A General Review. Diagn. Microbiol. Infect. Dis. 2020, 98, 115176. [Google Scholar] [CrossRef] [PubMed]
- Jagaran, K.; Singh, M. Nanomedicine for COVID-19: Potential of Copper Nanoparticles. Biointerface Res. Appl. Chem. 2020, 11, 10716–10728. [Google Scholar] [CrossRef]
- Govind, V.; Bharadwaj, S.; Sai Ganesh, M.R.; Vishnu, J.; Shankar, K.V.; Shankar, B.; Rajesh, R. Antiviral Properties of Copper and Its Alloys to Inactivate Covid-19 Virus: A Review. BioMetals 2021, 34, 1217–1235. [Google Scholar] [CrossRef] [PubMed]
- Lin, N.; Verma, D.; Saini, N.; Arbi, R.; Munir, M.; Jovic, M.; Turak, A. Antiviral Nanoparticles for Sanitizing Surfaces: A Roadmap to Self-Sterilizing against COVID-19. Nano Today 2021, 40, 101267. [Google Scholar] [CrossRef]
- Puchkova, L.V.; Kiseleva, I.V.; Polishchuk, E.V.; Broggini, M.; Ilyechova, E.Y. The Crossroads between Host Copper Metabolism and Influenza Infection. Int. J. Mol. Sci. 2021, 22, 5498. [Google Scholar] [CrossRef]
- Rani, I.; Goyal, A.; Bhatnagar, M.; Manhas, S.; Goel, P.; Pal, A.; Prasad, R. Potential Molecular Mechanisms of Zinc- and Copper-Mediated Antiviral Activity on COVID-19. Nutr. Res. 2021, 92, 109–128. [Google Scholar] [CrossRef] [PubMed]
- Tortella, G.R.; Pieretti, J.C.; Rubilar, O.; Fernández-Baldo, M.; Benavides-Mendoza, A.; Diez, M.C.; Seabra, A.B. Silver, Copper and Copper Oxide Nanoparticles in the Fight against Human Viruses: Progress and Perspectives. Crit. Rev. Biotechnol. 2022, 42, 431–449. [Google Scholar] [CrossRef]
- Ramos-Zúñiga, J.; Bruna, N.; Pérez-Donoso, J.M. Toxicity Mechanisms of Copper Nanoparticles and Copper Surfaces on Bacterial Cells and Viruses. Int. J. Mol. Sci. 2023, 24, 10503. [Google Scholar] [CrossRef]
- Zakharova, O.V.; Vasyukova, I.A.; Gusev, A.A. Metal-Based Nanoparticles for the Diagnostics, Therapy, and Prevention of Viral Infections. Nanobiotechnol. Rep. 2023, 18, 165–188. [Google Scholar] [CrossRef]
- Albalawi, S.A.; Albalawi, R.A.; Albalawi, A.A.; Alanazi, R.F.; Almahlawi, R.M.; Alhwity, B.S.; Alatawi, B.D.; Elsherbiny, N.; Alqifari, S.F.; Abdel-Maksoud, M.S. The Possible Mechanisms of Cu and Zn in the Treatment and Prevention of HIV and COVID-19 Viral Infection. Biol. Trace Elem. Res. 2024, 202, 1524–1538. [Google Scholar] [CrossRef]
- Gerwien, F.; Skrahina, V.; Kasper, L.; Hube, B.; Brunke, S. Metals in Fungal Virulence. FEMS Microbiol. Rev. 2018, 42, fux050. [Google Scholar] [CrossRef]
- Robinson, J.R.; Isikhuemhen, O.S.; Anike, F.N. Fungal–Metal Interactions: A Review of Toxicity and Homeostasis. J. Fungi 2021, 7, 225. [Google Scholar] [CrossRef]
- Amiri, M.R.; Alavi, M.; Taran, M.; Kahrizi, D. Antibacterial, Antifungal, Antiviral, and Photocatalytic Activities of TiO 2 Nanoparticles, Nanocomposites, and Bio-Nanocomposites: Recent Advances and Challenges. J. Public Health Res. 2022, 11, 227990362211041. [Google Scholar] [CrossRef]
- Gurunathan, S.; Lee, A.R.; Kim, J.H. Antifungal Effect of Nanoparticles against COVID-19 Linked Black Fungus: A Perspective on Biomedical Applications. Int. J. Mol. Sci. 2022, 23, 12526. [Google Scholar] [CrossRef]
- Pereira, D.; Carreira, T.S.; Alves, N.; Sousa, Â.; Valente, J.F.A. Metallic Structures: Effective Agents to Fight Pathogenic Microorganisms. Int. J. Mol. Sci. 2022, 23, 1165. [Google Scholar] [CrossRef]
- Alselami, A.; Drummond, R.A. How Metals Fuel Fungal Virulence, yet Promote Anti-Fungal Immunity. Dis. Model. Mech. 2023, 16, dmm050393. [Google Scholar] [CrossRef]
- Bellere, A.D.; Oh, S.; Zheng, S.; Fang, M.; Zuela, E.; Yi, T.-H. Fungal Wonders: A Perspective on Various Fungal Benefits to Mankind. Food Res. 2023, 7, 69–76. [Google Scholar] [CrossRef]
- Huang, T.; Li, X.; Maier, M.; O’Brien-Simpson, N.M.; Heath, D.E.; O’Connor, A.J. Using Inorganic Nanoparticles to Fight Fungal Infections in the Antimicrobial Resistant Era. Acta Biomater. 2023, 158, 56–79. [Google Scholar] [CrossRef] [PubMed]
- Madkhali, O.A. A Comprehensive Review on Potential Applications of Metallic Nanoparticles as Antifungal Therapies to Combat Human Fungal Diseases. Saudi Pharm. J. 2023, 31, 101733. [Google Scholar] [CrossRef] [PubMed]
- Shinde, B.H.; Inamdar, S.N.; Nalawade, S.A.; Chaudhari, S.B. A Systematic Review on Antifungal and Insecticidal Applications of Biosynthesized Metal Nanoparticles. Mater. Today Proc. 2023, 73, 412–417. [Google Scholar] [CrossRef]
- Frezza, M.; Hindo, S.; Chen, D.; Davenport, A.; Schmitt, S.; Tomco, D.; Ping Dou, Q. Novel Metals and Metal Complexes as Platforms for Cancer Therapy. Curr. Pharm. Des. 2010, 16, 1813–1825. [Google Scholar] [CrossRef]
- Denoyer, D.; Masaldan, S.; La Fontaine, S.; Cater, M.A. Targeting Copper in Cancer Therapy: ‘Copper That Cancer’. Metallomics 2015, 7, 1459–1476. [Google Scholar] [CrossRef]
- Shao, S.; Si, J.; Shen, Y. Copper as the Target for Anticancer Nanomedicine. Adv. Ther. 2019, 2, 1800147. [Google Scholar] [CrossRef]
- Lelièvre, P.; Sancey, L.; Coll, J.-L.; Deniaud, A.; Busser, B. The Multifaceted Roles of Copper in Cancer: A Trace Metal Element with Dysregulated Metabolism, but Also a Target or a Bullet for Therapy. Cancers 2020, 12, 3594. [Google Scholar] [CrossRef] [PubMed]
- Sharma, M.; Sharma, A.; Majumder, S. Synthesis, Microbial Susceptibility and Anti-Cancerous Properties of Copper Oxide Nanoparticles- Review. Nano Express 2020, 1, 012003. [Google Scholar] [CrossRef]
- Guan, D.; Zhao, L.; Shi, X.; Ma, X.; Chen, Z. Copper in Cancer: From Pathogenesis to Therapy. Biomed. Pharmacother. 2023, 163, 114791. [Google Scholar] [CrossRef] [PubMed]
- Ji, P.; Wang, P.; Chen, H.; Xu, Y.; Ge, J.; Tian, Z.; Yan, Z. Potential of Copper and Copper Compounds for Anticancer Applications. Pharmaceuticals 2023, 16, 234. [Google Scholar] [CrossRef] [PubMed]
- Wang, X.; Zhou, M.; Liu, Y.; Si, Z. Cope with Copper: From Copper Linked Mechanisms to Copper-Based Clinical Cancer Therapies. Cancer Lett. 2023, 561, 216157. [Google Scholar] [CrossRef] [PubMed]
- Yang, S.; Song, Y.; Hu, Y.; Chen, H.; Yang, D.; Song, X. Multifaceted Roles of Copper Ions in Anticancer Nanomedicine. Adv. Healthc. Mater. 2023, 12, 2300410. [Google Scholar] [CrossRef] [PubMed]
- Yang, Y.; Li, M.; Chen, G.; Liu, S.; Guo, H.; Dong, X.; Wang, K.; Geng, H.; Jiang, J.; Li, X. Dissecting Copper Biology and Cancer Treatment: ‘Activating Cuproptosis or Suppressing Cuproplasia’. Coord. Chem. Rev. 2023, 495, 215395. [Google Scholar] [CrossRef]
- Schuschke, L.A.; Saari, J.T.; Miller, F.N.; Schuschke, D.A. Hemostatic Mechanisms in Marginally Copper-Deficient Rats. J. Lab. Clin. Med. 1995, 125, 748–753. [Google Scholar]
- Belozerskaya, G.G.; Makarov, V.A.; Zhidkov, E.A.; Malykhina, L.S.; Sergeeva, O.A.; Ter-Arutyunyants, A.A.; Makarova, L.V. Local Hemostatics (A Review). Pharm. Chem. J. 2006, 40, 353–359. [Google Scholar] [CrossRef]
- Ashfaq, M.; Verma, N.; Khan, S. Highly Effective Cu/Zn-Carbon Micro/Nanofiber-Polymer Nanocomposite-Based Wound Dressing Biomaterial against the P. Aeruginosa Multi- and Extensively Drug-Resistant Strains. Mater. Sci. Eng. C 2017, 77, 630–641. [Google Scholar] [CrossRef] [PubMed]
- Saran, M.; Vyas, S.; Mathur, M.; Bagaria, A. Green Synthesis and Characterisation of CuNPs: Insights into Their Potential Bioactivity. IET Nanobiotechnol. 2018, 12, 357–364. [Google Scholar] [CrossRef]
- Van Rensburg, M.; Van Rooy, M.; Bester, M.; Serem, J.; Venter, C.; Oberholzer, H. Oxidative and Haemostatic Effects of Copper, Manganese and Mercury, Alone and in Combination at Physiologically Relevant Levels: An Ex Vivo Study. Hum. Exp. Toxicol. 2019, 38, 419–433. [Google Scholar] [CrossRef] [PubMed]
- Kong, Y.; Hou, Z.; Zhou, L.; Zhang, P.; Ouyang, Y.; Wang, P.; Chen, Y.; Luo, X. Injectable Self-Healing Hydrogels Containing CuS Nanoparticles with Abilities of Hemostasis, Antibacterial Activity, and Promoting Wound Healing. ACS Biomater. Sci. Eng. 2021, 7, 335–349. [Google Scholar] [CrossRef] [PubMed]
- Tarantino, G.; Citro, V.; Capone, D.; Gaudiano, G.; Sinatti, G.; Santini, S.J.; Balsano, C. Copper Concentrations Are Prevalently Associated with Antithrombin III, but Also with Prothrombin Time and Fibrinogen in Patients with Liver Cirrhosis: A Cross-Sectional Retrospective Study. J. Trace Elem. Med. Biol. 2021, 68, 126802. [Google Scholar] [CrossRef] [PubMed]
- Alasvand, N.; Behnamghader, A.; Milan, P.B.; Simorgh, S.; Mobasheri, A.; Mozafari, M. Tissue-Engineered Small-Diameter Vascular Grafts Containing Novel Copper-Doped Bioactive Glass Biomaterials to Promote Angiogenic Activity and Endothelial Regeneration. Mater. Today Bio 2023, 20, 100647. [Google Scholar] [CrossRef] [PubMed]
- Liu, G.; Zu, M.; Wang, L.; Xu, C.; Zhang, J.; Reis, R.L.; Kundu, S.C.; Xiao, B.; Duan, L.; Yang, X. CaO2–Cu2O Micromotors Accelerate Infected Wound Healing through Antibacterial Functions, Hemostasis, Improved Cell Migration, and Inflammatory Regulation. J. Mater. Chem. B 2024, 12, 250–263. [Google Scholar] [CrossRef] [PubMed]
- Wang, M.; Zhang, W.; Wang, C.; Xiao, L.; Yu, L.; Fan, J. Hemostatic and Antibacterial Calcium–Copper Zeolite Gauze for Infected Wound Healing. RSC Adv. 2024, 14, 878–888. [Google Scholar] [CrossRef] [PubMed]
- Harris, E.D. A Requirement for Copper in Angiogenesis. Nutr. Rev. 2004, 62, 60–64. [Google Scholar] [CrossRef]
- Finney, L.; Vogt, S.; Fukai, T.; Glesne, D. Copper and angiogenesis: Unravelling a relationship key to cancer progression. Clin. Exp. Pharmacol. Physiol. 2009, 36, 88–94. [Google Scholar] [CrossRef]
- D’Andrea, L.D.; Romanelli, A.; Di Stasi, R.; Pedone, C. Bioinorganic Aspects of Angiogenesis. Dalton Trans. 2010, 39, 7625. [Google Scholar] [CrossRef] [PubMed]
- Saghiri, M.A.; Asatourian, A.; Orangi, J.; Sorenson, C.M.; Sheibani, N. Functional Role of Inorganic Trace Elements in Angiogenesis—Part II: Cr, Si, Zn, Cu, and S. Crit. Rev. Oncol. Hematol. 2015, 96, 143–155. [Google Scholar] [CrossRef] [PubMed]
- Devi, S.R.B.; Dhivya, M.A.; Sulochana, K.N. Copper Transporters and Chaperones: Their Function on Angiogenesis and Cellular Signalling. J. Biosci. 2016, 41, 487–496. [Google Scholar] [CrossRef] [PubMed]
- Jacobs, A.; Renaudin, G.; Forestier, C.; Nedelec, J.-M.; Descamps, S. Biological Properties of Copper-Doped Biomaterials for Orthopedic Applications: A Review of Antibacterial, Angiogenic and Osteogenic Aspects. Acta Biomater. 2020, 117, 21–39. [Google Scholar] [CrossRef] [PubMed]
- Xiao, Y.; Wang, T.; Song, X.; Yang, D.; Chu, Q.; Kang, Y.J. Copper Promotion of Myocardial Regeneration. Exp. Biol. Med. 2020, 245, 911–921. [Google Scholar] [CrossRef] [PubMed]
- Cucci, L.M.; Satriano, C.; Marzo, T.; La Mendola, D. Angiogenin and Copper Crossing in Wound Healing. Int. J. Mol. Sci. 2021, 22, 10704. [Google Scholar] [CrossRef] [PubMed]
- Marzo, T.; La Mendola, D. The Effects on Angiogenesis of Relevant Inorganic Chemotherapeutics. Curr. Top. Med. Chem. 2021, 21, 73–86. [Google Scholar] [CrossRef] [PubMed]
- Šalandová, M.; Van Hengel, I.A.J.; Apachitei, I.; Zadpoor, A.A.; Van Der Eerden, B.C.J.; Fratila-Apachitei, L.E. Inorganic Agents for Enhanced Angiogenesis of Orthopedic Biomaterials. Adv. Healthc. Mater. 2021, 10, 2002254. [Google Scholar] [CrossRef] [PubMed]
- Lüthen, F.; Bergemann, C.; Bulnheim, U.; Prinz, C.; Neumann, H.G.; Podbielski, A.; Bader, R.; Rychly, J. A Dual Role of Copper on the Surface of Bone Implants. Mater. Sci. Forum 2010, 638–642, 600–605. [Google Scholar] [CrossRef]
- Ryan, E.J.; Ryan, A.J.; González-Vázquez, A.; Philippart, A.; Ciraldo, F.E.; Hobbs, C.; Nicolosi, V.; Boccaccini, A.R.; Kearney, C.J.; O’Brien, F.J. Collagen Scaffolds Functionalised with Copper-Eluting Bioactive Glass Reduce Infection and Enhance Osteogenesis and Angiogenesis Both in Vitro and in Vivo. Biomaterials 2019, 197, 405–416. [Google Scholar] [CrossRef]
- Eivazzadeh-Keihan, R.; Bahojb Noruzi, E.; Khanmohammadi Chenab, K.; Jafari, A.; Radinekiyan, F.; Hashemi, S.M.; Ahmadpour, F.; Behboudi, A.; Mosafer, J.; Mokhtarzadeh, A.; et al. Metal-based Nanoparticles for Bone Tissue Engineering. J. Tissue Eng. Regen. Med. 2020, 14, 1687–1714. [Google Scholar] [CrossRef] [PubMed]
- Bosch-Rué, E.; Diez-Tercero, L.; Giordano-Kelhoffer, B.; Delgado, L.M.; Bosch, B.M.; Hoyos-Nogués, M.; Mateos-Timoneda, M.A.; Tran, P.A.; Gil, F.J.; Perez, R.A. Biological Roles and Delivery Strategies for Ions to Promote Osteogenic Induction. Front. Cell Dev. Biol. 2021, 8, 614545. [Google Scholar] [CrossRef] [PubMed]
- Ghosh, S.; Webster, T.J. Metallic Nanoscaffolds as Osteogenic Promoters: Advances, Challenges and Scope. Metals 2021, 11, 1356. [Google Scholar] [CrossRef]
- Pantulap, U.; Arango-Ospina, M.; Boccaccini, A.R. Bioactive Glasses Incorporating Less-Common Ions to Improve Biological and Physical Properties. J. Mater. Sci. Mater. Med. 2022, 33, 3. [Google Scholar] [CrossRef] [PubMed]
- Shen, Q.; Qi, Y.; Kong, Y.; Bao, H.; Wang, Y.; Dong, A.; Wu, H.; Xu, Y. Advances in Copper-Based Biomaterials With Antibacterial and Osteogenic Properties for Bone Tissue Engineering. Front. Bioeng. Biotechnol. 2022, 9, 795425. [Google Scholar] [CrossRef] [PubMed]
- Shimabukuro, M.; Hayashi, K.; Kishida, R.; Tsuchiya, A.; Ishikawa, K. Surface Functionalization with Copper Endows Carbonate Apatite Honeycomb Scaffold with Antibacterial, Proangiogenic, and pro-Osteogenic Activities. Biomater. Adv. 2022, 135, 212751. [Google Scholar] [CrossRef] [PubMed]
- Amantay, M.; Ma, Y.; Chen, L.; Osman, H.; Mengping, L.; Jiang, T.; Zhou, T.; Ye, T.; Wang, Y. Electrospinning Fibers Modified with Near Infrared Light-Excited Copper Nanoparticles for Antibacterial and Bone Regeneration. Adv. Mater. Interfaces 2023, 10, 2300113. [Google Scholar] [CrossRef]
- Heliopoulos, N.S.; Papageorgiou, S.K.; Galeou, A.; Favvas, E.P.; Katsaros, F.K.; Stamatakis, K. Effect of Copper and Copper Alginate Treatment on Wool Fabric. Study of Textile and Antibacterial Properties. Surf. Coat. Technol. 2013, 235, 24–31. [Google Scholar] [CrossRef]
- Ivankovic, T.; Rajic, A.; Ercegovic Razic, S.; Rolland Du Roscoat, S.; Skenderi, Z. Antibacterial Properties of Non-Modified Wool, Determined and Discussed in Relation to ISO 20645:2004 Standard. Molecules 2022, 27, 1876. [Google Scholar] [CrossRef]
- Ruberto, M.F.; Marongiu, F.; Barcellona, D. Performance and Interpretation of Clot Waveform Analysis. In Hemostasis and Thrombosis; Favaloro, E.J., Gosselin, R.C., Eds.; Methods in Molecular Biology; Springer: New York, NY, USA, 2023; Volume 2663, pp. 163–173. ISBN 978-1-07-163174-4. [Google Scholar]
- EN ISO 3801:1977; Textiles—Woven Fabrics—Determination of Mass per Unit Length and Mass per Unit Area. International Organization for Standardization: Geneva, Switzerland, 1977.
- EN ISO 3071:2020; Textiles—Determination of pH of Aqueous Extract. International Organization for Standardization: Geneva, Switzerland, 2020.
- EN ISO 3074:2014; Wool—Determination of Dichloromethane-Soluble Matter in Combed Sliver. International Organization for Standardization: Geneva, Switzerland, 2014.
- EN ISO 5084:1996; Textiles—Determination of Thickness of Textiles and Textile Products. International Organization for Standardization: Geneva, Switzerland, 1996.
- Analytical Methods for Atomic Absorption Spectroscopy. The Perkin-Elmer Corporation, 1996, p. 41. Available online: www.lasalle.edu/ (accessed on 5 June 2024).
- EN ISO 105-C06:2010; Textiles-Tests for Color Fastness—Part C06: Color Fastness to Domestic and Commercial Laundering. International Organization for Standardization: Geneva, Switzerland, 2010.
- EN ISO 15632:2021; Microbeam Analysis—Selected Instrumental Performance Parameters for the Specification and Checking of Energy-Dispersive X-ray Spectrometers (EDS) for Use with a Scanning Electron Microscope (SEM) or an Electron Probe Microanalyser (EPMA). International Organization for Standardization: Geneva, Switzerland, 2021.
- EN ISO 20645:2006; Textile Fabrics—Determination of Antibacterial Activity—Agar Diffusion Plate Test. International Organization for Standardization: Geneva, Switzerland, 2006.
- EN 14119: 2003 point 10.5 (B2); Testing of Textiles. Evaluation of the Action of Microfungi. Visual Method. European Committee for Standardization (CEN): Brussles, Belgium, 2003.
- Juszczak, M.; Das, S.; Kosińska, A.; Rybarczyk-Pirek, A.J.; Wzgarda-Raj, K.; Tokarz, P.; Vasudevan, S.; Chworos, A.; Woźniak, K.; Rudolf, B. Piano-Stool Ruthenium(II) Complexes with Maleimide and Phosphine or Phosphite Ligands: Synthesis and Activity against Normal and Cancer Cells. Dalton Trans. 2023, 52, 4237–4250. [Google Scholar] [CrossRef]
- Zhang, N.; Wang, Q.; Yuan, J.; Cui, L.; Wang, P.; Yu, Y.; Fan, X. Highly Efficient and Eco-Friendly Wool Degradation by L-Cysteine-Assisted Esperase. J. Clean. Prod. 2018, 192, 433–442. [Google Scholar] [CrossRef]
- Rippon, J.A.; Christoe, J.R.; Denning, R.J.; Evans, D.J.; Huson, M.G.; Lamb, P.R.; Millington, K.R.; Pierlot, A.P. Wool: Structure, Properties, and Processing. In Encyclopedia of Polymer Science and Technology; Mark, H.F., Ed.; John Wiley & Sons: Hoboken, NJ, USA, 2016; pp. 1–46. ISBN 978-1-118-63389-2. [Google Scholar]
- Giteru, S.G.; Ramsey, D.H.; Hou, Y.; Cong, L.; Mohan, A.; Bekhit, A.E.A. Wool Keratin as a Novel Alternative Protein: A Comprehensive Review of Extraction, Purification, Nutrition, Safety, and Food Applications. Compr. Rev. Food Sci. Food Saf. 2023, 22, 643–687. [Google Scholar] [CrossRef] [PubMed]
- Shorland, F.B.; Gray, J.M. The Preparation of Nutritious Protein from Wool. Br. J. Nutr. 1970, 24, 717–725. [Google Scholar] [CrossRef] [PubMed]
- Zhao, X.; Wang, H.; Zhao, R.G.; Yang, W.S. Self-assembly of amino acids on the Cu(001) surface. Mater. Sci. Eng. C 2001, 16, 41–50. [Google Scholar] [CrossRef]
- Rankin, R.B.; Sholl, D.S. Structures of glycine, enantiopure alanine, and racemic alanine adlayers; on Cu(110) and Cu(100) surfaces. J. Phys. Chem. B 2005, 109, 16764–16773. [Google Scholar] [CrossRef] [PubMed]
- Cheong, W.Y.; Huang, Y.; Dangaria, N.; Gellman, A.J. Probing enantioselectivity on chirally modified Cu(110), Cu(100), and Cu(111) surfaces. Langmuir 2010, 26, 16412–16423. [Google Scholar] [CrossRef] [PubMed]
- Gladys, M.J.; Stevens, A.V.; Scott, N.R.; Glenn, J.; Batchelor, D.; Held, G. Enantiospecific adsorption of alanine on the chiral Cu(531) surface. J. Phys. Chem. C 2007, 111, 8331–8336. [Google Scholar] [CrossRef]
- Thomsen, L.; Wharmby, M.T.; Riley, D.P.; Held, G.; Gladys, M.J. The adsorption and stability of sulfur containing amino acids on Cu(531). Surf. Sci. 2009, 603, 1253–1261. [Google Scholar] [CrossRef]
- Ge, S.P.; Lu, C.; Zhao, R.G.; Chen, Q. Scanning tunneling microscopy investigation of leucine and asparagine adsorbed on Cu(111). Appl. Surf. Sci. 2006, 253, 2456–2459. [Google Scholar] [CrossRef]
- Karagoz, B.; Reinicker, A.; Gellman, A.J. Kinetics and mechanism of aspartic acid adsorption and its explosive decomposition on Cu(100). Langmuir 2019, 35, 2925–2933. [Google Scholar] [CrossRef]
- Totani, R.; Méthivier, C.; Cruguel, H.; Pradier, C.M.; Humblot, V. Deciphering the adsorption mechanisms of RGD subunits: L-Aspartic acid on Cu(110). J. Phys. Chem. C 2017, 121, 15842–15850. [Google Scholar] [CrossRef]
- Cramer, L.A.; Larson, A.; Daniels, A.S.; Sykes, E.C.H.; Gellman, A.J. Molecular origins of chiral amplification on an achiral surface: 2D monolayers of aspartic acid on Cu(111). ACS Nano 2023, 17, 5799–5807. [Google Scholar] [CrossRef]
- Kim, J.W.; Lee, Y.M.; Lee, S.M.; Son, M.J.; Kang, H.; Park, Y. Surface reaction of sulfur-containing amino acids on Cu(110). Langmuir 2010, 26, 5632–5636. [Google Scholar] [CrossRef]
- Kumar, D.; Jain, N.; Jain, V.; Rai, B. Amino acids as copper corrosion inhibitors: A density functional theory approach. App. Surf. Sci. 2020, 514, 145905. [Google Scholar] [CrossRef]
- Wang, C.; Luo, X.; Jia, Z. Linkage, charge state and layer of l-cysteine on copper surfaces. Colloids Surf. B Biointerfaces 2017, 160, 33–39. [Google Scholar] [CrossRef]
- Rodríguez-Zamora, P.; Cordero-Silis, C.A.; Fabila, J.; Luque-Ceballos, J.C.; Buendía, B.; Heredia-Barbero, A.; Garzón, I.L. Interaction mechanisms and interface configuration of cysteine adsorbed on gold, silver, and copper nanoparticles. Langmuir 2022, 38, 5418–5427. [Google Scholar] [CrossRef]
- Marti, E.M.; Methivier, C.; Dubot, P.; Pradier, C.M. Adsorption of (S)-histidine on Cu(110) and oxygen-covered Cu(110), a combined Fourier transform reflection absorption infrared spectroscopy and force field calculation study. J. Phys. Chem. B 2003, 107, 10785–10792. [Google Scholar] [CrossRef]
- Bouri, M.; Lekka, C. L-Glutamine coating on antibacterial cu surface by density functional theory. Crystals 2023, 13, 1698. [Google Scholar] [CrossRef]
- Barlow, S.M.; Kitching, K.J.; Haq, S.; Richardson, N.V. A study of glycine adsorption on a Cu(110) surface using reflection absorption infrared spectroscopy. Surf. Sci. 1998, 401, 322–335. [Google Scholar] [CrossRef]
- Booth, N.A.; Woodruff, D.P.; Schaff, O.; Gießel, T.; Lindsay, R.; Baumgärtel, P.; Bradshaw, A.M. Determination of the local structure of glycine adsorbed on Cu(110). Surf. Sci. 1998, 397, 258–269. [Google Scholar] [CrossRef]
- Hasselström, J.; Karis, O.; Weinelt, M.; Wassdahl, N.; Nilsson, A.; Nyberg, M.; Pettersson, L.G.M.; Samant, M.G.; Stöhr, J. The adsorption structure of glycine adsorbed on Cu(110); comparison with formate and acetate/Cu(110). Surf. Sci. 1998, 407, 221–236. [Google Scholar] [CrossRef]
- Carravetta, V.; Monti, S.; Li, C.; Ågren, H. Theoretical simulations of structure and X-ray photoelectron spectra of glycine and diglycine adsorbed on Cu(110). Langmuir 2013, 29, 10194–10204. [Google Scholar] [CrossRef]
- Zhao, X.; Zhao, R.G.; Yang, W.S. Scanning tunneling microscopy investigation of L-lysine adsorbed on Cu(001). Langmuir 2000, 16, 9812–9818. [Google Scholar] [CrossRef]
- Humblot, V.; Méthivier, C.; Raval, R.; Pradier, C.-M. Amino acid and peptides on Cu(110) surfaces: Chemical and structural analyses of L-lysine. Surf. Sci. 2007, 601, 4189–4194. [Google Scholar] [CrossRef]
- Tielens, F.; Humblot, V.; Pradier, C.-M. Elucidation of the low coverage chiral adsorption assembly of l-lysine on Cu(110) surface: A theoretical study. Surf. Sci. 2008, 602, 1032–1039. [Google Scholar] [CrossRef]
- Eralp, T.; Shavorskiy, A.; Held, G. The adsorption geometry and chemical state of lysine on Cu(110). Surf. Sci. 2011, 605, 468–472. [Google Scholar] [CrossRef]
- Méthivier, C.; Humblot, V.; Pradier, C.-M. L-Methionine adsorption on Cu(110), binding and geometry of the amino acid as a function of coverage. Surf. Sci. 2015, 632, 88–92. [Google Scholar] [CrossRef]
- Ghiringhelli, L.M.; Delle Site, L. Phenylalanine near inorganic surfaces: Conformational statistics vs specific chemistry. J. Amer. Chem. Soc. 2008, 130, 2634–2638. [Google Scholar] [CrossRef]
- Eralp, T.; Shavorskiy, A.; Zheleva, Z.V.; Held, G.; Kalashnyk, N.; Ning, Y.; Linderoth, T.R. Global and local expression of chirality in serine on the Cu(110) surface. Langmuir 2010, 26, 18841–18851. [Google Scholar] [CrossRef][Green Version]
- Eralp, T.; Ievins, A.; Shavorskiy, A.; Jenkins, S.J.; Held, G. The importance of attractive three-point interaction in enantioselective surface chemistry: Stereospecific adsorption of serine on the intrinsically chiral Cu(531) surface. J. Amer. Chem. Soc. 2012, 134, 9615–9621. [Google Scholar] [CrossRef]
- Lee, H.; Kim, H.S. Confirmation of initial stable adsorption structures of leucine and tyrosine adsorbed on a Cu(110) surface. Appl. Sci. 2020, 10, 1284. [Google Scholar] [CrossRef]
- Zhao, X.; Zhao, R.G.; Yang, W.S. Self-assembly of L-tryptophan on the Cu(001) surface. Langmuir 2002, 18, 433–438. [Google Scholar] [CrossRef]
- Wang, D.; Xu, Q.-M.; Wan, L.-J.; Bai, C.-L.; Jin, G. Adsorption of enantiomeric and racemic tyrosine on Cu(111): A scanning tunneling microscopy study. Langmuir 2003, 19, 1958–1962. [Google Scholar] [CrossRef]
- Feyer, V.; Plekan, O.; Tsud, N.; Lyamayev, V.; Cháb, V.; Matolín, V.; Prince, K.C.; Carravetta, V. Adsorption structure of glycyl-glycine on Cu(110). J. Phys. Chem. C 2010, 114, 10922–10931. [Google Scholar] [CrossRef]
- Monti, S.; Carravetta, V.; Li, C.; Ågren, H. A computational study of the adsorption and reactive dynamics of diglycine on Cu(110). J. Phys. Chem. C 2014, 118, 3610–3619. [Google Scholar] [CrossRef]
- Methivier, C.; Humblot, V.; Pradier, C.-M. UHV deposition of the Gly-Pro dipeptide on Cu(110) by sublimation or electrospray ionization. J. Phys. Chem. C 2016, 120, 27364–27368. [Google Scholar] [CrossRef][Green Version]
- Stensgaard, I. Adsorption of di-L-alanine on Cu(110) investigated with scanning tunneling microscopy. Surface Sci. 2003, 545, L747–L752. [Google Scholar] [CrossRef]
- Tomba, G.; Lingenfelder, M.; Costantini, G.; Kern, K.; Klappenberger, F.; Barth, J.V.; Ciacchi, L.C.; De Vita, A. Structure and energetics of diphenylalanine self-assembling on Cu(110)+. J. Phys. Chem. A 2007, 111, 12740–12748. [Google Scholar] [CrossRef][Green Version]
- Mervinetsky, E.; Alshanski, I.; Hamo, Y.; Sandonas, L.M.; Dianat, A.; Buchwald, J.; Gutierrez, R.; Cuniberti, G.; Hurevich, M.; Yitzchaik, S. Copper induced conformational changes of tripeptide monolayer based impedimetric biosensor. Biosensor. Sci. Rep. 2017, 7, 9498. [Google Scholar] [CrossRef]
- Gellini, C.; Sabatino, G.; Papini, A.M.; Muniz-Miranda, M. SERS study of a tetrapeptide based on histidine and glycine residues, adsorbed on copper/silver colloidal nanoparticles. J. Raman Spectrosc. 2014, 45, 418–423. [Google Scholar] [CrossRef]
- Mauri, E.; Sacchetti, A.; Rossi, F. The synthesis of RGD-functionalized hydrogels as a tool for therapeutic applications. J. Vis. Exp. 2016, 116, e54445. [Google Scholar] [CrossRef]
- Méthivier, C.; Cornette, P.; Costa, D.; Landoulsi, J. Electrospray ion beam deposition of small peptides on solid surfaces: A molecular level description of the glutathione/copper interface. Appl. Surface Sci. 2023, 612, 155895. [Google Scholar] [CrossRef]
- Kobayashi, Y.; Abe, Y.; Maeda, T.; Yasuda, Y.; Morita, T. A metal–metal bonding process using metallic copper nanoparticles produced by reduction of copper oxide nanoparticles. J. Mater. Res. Technol. 2014, 3, 114–121. [Google Scholar] [CrossRef]
- Gond-Charton, P.; Imbert, B.; Benaissa, L.; Carron, V.; Verdier, M. Kinetics of low temperature direct copper–copper bonding. Microsyst. Technol. 2015, 21, 995–1001. [Google Scholar] [CrossRef]
- Lepetit, C.; Fau, P.; Fajerwerg, K.; Kahn, M.L.; Silvi, B. Topological analysis of the metal-metal bond: A tutorial review. Coord. Chem. Rev. 2017, 345, 150–181. [Google Scholar] [CrossRef]
- Mou, Y.; Peng, Y.; Zhang, Y.; Cheng, H.; Chen, M. Cu-Cu bonding enhancement at low temperature by using carboxylic acid surface-modified Cu nanoparticles. Mater. Lett. 2018, 227, 179–183. [Google Scholar] [CrossRef]
- Wilson, R.J.; Lichtenberger, N.; Weinert, B.; Dehnen, S. Intermetalloid and heterometallic clusters combining p-block (semi)metals with d- or f-block metals. Chem. Rev. 2019, 119, 8506–8554. [Google Scholar] [CrossRef]
- Lin, P.F.; Tran, D.P.; Liu, H.C.; Li, Y.Y.; Chen, C. Interfacial characterization of low-temperature Cu-to-Cu direct bonding with chemical mechanical planarized nanotwinned Cu films. Materials 2022, 15, 937. [Google Scholar] [CrossRef]
- Arai, S.; Nakajima, S.; Shimizu, M.; Shimizu, M.; Aizawa, M.; Kiyoshi, O. Direct Cu-Cu bonding by low-temperature sintering using three-dimensional nanostructured plated Cu films. Mater. Today Commun. 2023, 35, 105790. [Google Scholar] [CrossRef]
- Yao, D.; Wang, Y.; Li, Y.; Li, A.; Zhen, Z.; Lv, J.; Sun, F.; Yang, R.; Luo, J.; Jiang, Z.; et al. Scalable synthesis of Cu clusters for remarkable selectivity control of intermediates in consecutive hydrogenation. Nat. Commun. 2023, 14, 1123. [Google Scholar] [CrossRef]
- Paul, S.; Hewitt, A.; Rana, S.; Goswami, P. Development of novel parameters for characterising scale morphology of wool fibre and its correlation with dye diffusion coefficient of acid dye. Sci. Rep. 2023, 13, 18444. [Google Scholar] [CrossRef] [PubMed]
- Xu, W.; Ke, G.; Wu, J.; Wang, X. Modification of wool fiber using steam explosion. Eur. Polym. J. 2006, 42, 2168–2173. [Google Scholar] [CrossRef]
- Essaket, M.; Wazna, M.E.; Boukhriss, A.; Essaket, I.; Bouari, A.E.; Cherkaoui, O.; Maliki, A.E. A Comparative Study and Thermophysical Characterization of Wool Fiber from Different Regions of Morocco. Biomass Convers. Biorefinery 2023. [Google Scholar] [CrossRef]
- Bläker, C.; Muthmann, J.; Pasel, C.; Bathen, D. Characterization of Activated Carbon Adsorbents—State of the Art and Novel Approaches. ChemBioEng Rev. 2019, 6, 119–138. [Google Scholar] [CrossRef]
- Airaksinen, S. Role of Excipients in Moisture Sorption and Physical Stability of Solid Pharmaceutical Formulations. Ph.D. Thesis, Faculty of Pharmacy of the University of Helsinki, Helsinki University Printing House, Helsinki, Finland, 2005. [Google Scholar]
- Thommes, M.; Kaneko, K.; Neimark, A.V.; Olivier, J.P.; Rodriguez-Reinoso, F.; Rouquerol, J.; Sing, K.S.W. Physisorption of Gases, with Special Reference to the Evaluation of Surface Area and Pore Size Distribution (IUPAC Technical Report). Pure Appl. Chem. 2015, 87, 1051–1069. [Google Scholar] [CrossRef]
- Qi, L.; Tang, X.; Wang, Z.; Peng, X. Pore Characterization of Different Types of Coal from Coal and Gas Outburst Disaster Sites Using Low Temperature Nitrogen Adsorption Approach. Int. J. Min. Sci. Technol. 2017, 27, 371–377. [Google Scholar] [CrossRef]
- Boinovich, L.B.; Kaminsky, V.V.; Domantovsky, A.G.; Emelyanenko, K.A.; Aleshkin, A.V.; Zulkarneev, E.R.; Kiseleva, I.A.; Emelyanenko, A.M. Bactericidal activity of superhydrophobic and superhydrophilic copper in bacterial dispersions. Langmuir 2019, 35, 2832–2841. [Google Scholar] [CrossRef] [PubMed]
- Chang, T.; Prasath Babu, R.; Zhao, C.W.; Johnson, M.; Hedström, P.; Odnevall, I.; Leygraf, C. High-resolution microscopical studies of contact killing mechanisms on copper-based surfaces. ACS Appl. Mater. Interfaces 2021, 13, 49402–49413. [Google Scholar] [CrossRef] [PubMed]
- Hans, M.; Mathews, S.; Mucklich, F.; Solioza, M. Physicochemical properties of copper important for its antibacterial activity and development of a unified model. Biointerphases 2016, 11, 018902. [Google Scholar] [CrossRef]
- Kiranmayee, M.; Rajesh, N.; Vidya Vani, M.; Khadri, H.; Suresh, A.M.; Chinni, V.; Ramachawolran, G.; Riazunnisa, K.; Moussa, A.Y. Green synthesis of Piper nigrum copper-based nanoparticles: In silico study and ADMET analysis to assess their antioxidant, antibacterial, and cytotoxic effects. Front. Chem. 2023, 11, 1218588. [Google Scholar] [CrossRef]
- Ejidike, I.P.; Ijimdiya, R.U.; Emmanuel-Akerele, H.A.; Emmanuel, G.C.; Ejidike, O.M.; Bamigboye, M.O.; Seyinde, D.O.; Olaleru, A.; Tanimowo, W.O.; Awolope, R.O. Biosynthesis, characterization, and antimicrobial assessment of metal nanoparticles from Dryopteris Manniana (Hook.) C. Chr leaf extract. Bull. Pharmac. Sci. Assiut 2023, 46, 225–238. [Google Scholar] [CrossRef]
- Raspolli Galletti, A.M.; Antonetti, C.; Marracci, M.; Piccinelli, F.; Tellini, B. Novel microwave-synthesis of Cu nanoparticles in the absence of any stabilizing agent and their antibacterial and antistatic applications. Appl. Surf. Sci. 2013, 280, 610–618. [Google Scholar] [CrossRef]
- Karthik, A.D.; Geetha, K. Synthesis of copper precursor, copper and its oxide nanoparticles by green chemical reduction method and its antimicrobial activity. J. Appl. Pharmac. Sci. 2013, 3, 16–21. [Google Scholar]
- Rad, M.; Taran, M.; Alavi, M. Effect of incubation time, CuSO4 and glucose concentrations on biosynthesis of copper oxide (CuO) nanoparticles with rectangular shape and antibacterial activity: Taguchi method approach. Nano Biomed. Eng. 2018, 10, 25–33. [Google Scholar] [CrossRef]
- Ramyadevi, J.; Jeyasubramanian, K.; Marikani, A.; Rajakumar, G.; Rahuman, A.A. Synthesis and antimicrobial activity of copper nanoparticles. Mater. Lett. 2012, 71, 114–116. [Google Scholar] [CrossRef]
- Rajamohan, R.; Raorane, C.J.; Kim, S.-C.; Ashokkumar, S.; Lee, Y.R. Novel Microwave synthesis of copper oxide nanoparticles and appraisal of the antibacterial application. Micromachines 2023, 14, 456. [Google Scholar] [CrossRef]
- Ivanauskas, R.; Ancutiene, I.; Milašienė, D.; Ivanauskas, A.; Bronusiene, A. Effect of reducing agent on characteristics and antibacterial activity of copper-containing particles in textile materials. Materials 2022, 15, 7623. [Google Scholar] [CrossRef] [PubMed]
- Zhao, J.; Yang, G.; Zhang, C.; Zhang, Y.; Zhang, S.; Zhang, P. Synthesis of water-soluble Cu nanoparticles and evaluation of their tribological properties and thermal conductivity as a water-based additive. Friction 2019, 7, 246–259. [Google Scholar] [CrossRef]
- Song, Y.; Xie, X.; Liu, Y.; Zhu, Z.; Sun, L. Nanoscale Study of DNA–Cu2+ Interactions by Liquid-Cell Electron Microscopy. ACS Omega 2023, 8, 26325–26331. [Google Scholar] [CrossRef]
- Erxleben, A. Interactions of Copper Complexes with Nucleic Acids. Coord. Chem. Rev. 2018, 360, 92–121. [Google Scholar] [CrossRef]
- De Souza, Í.P.; Machado, B.D.P.; De Carvalho, A.B.; Binatti, I.; Krambrock, K.; Molphy, Z.; Kellett, A.; Pereira-Maia, E.C.; Silva-Caldeira, P.P. Exploring the DNA Binding, Oxidative Cleavage, and Cytotoxic Properties of New Ternary Copper(II) Compounds Containing 4-Aminoantipyrine and N,N-Heterocyclic Co-Ligands. J. Mol. Struct. 2019, 1178, 18–28. [Google Scholar] [CrossRef]
- Pham, A.N.; Xing, G.; Miller, C.J.; Waite, T.D. Fenton-like Copper Redox Chemistry Revisited: Hydrogen Peroxide and Superoxide Mediation of Copper-Catalyzed Oxidant Production. J. Catal. 2013, 301, 54–64. [Google Scholar] [CrossRef]
- Freudenthal, B.D. Base Excision Repair of Oxidative DNA Damage from Mechanism to Disease. Front. Biosci. 2017, 22, 1493–1522. [Google Scholar] [CrossRef]
- Shim, S.-Y.; Kim, H.-S. Oxidative Stress and the Antioxidant Enzyme System in the Developing Brain. Korean J. Pediatr. 2013, 56, 107. [Google Scholar] [CrossRef]
- Chen, X.; Chen, J.; Huang, N. The Structure, Formation, and Effect of Plasma Protein Layer on the Blood Contact Materials: A Review. Biosurf. Biotribol. 2022, 8, 1–14. [Google Scholar] [CrossRef]
- Hanson, S.R.; Tucker, E.I.; Latour, R.A. 2.2.6—Blood Coagulation and Blood–Material Interactions. In Biomaterials Science, 4th ed.; Wagner, W.R., Sakiyama-Elbert, S.E., Zhang, G., Yaszemski, M.J., Eds.; Academic Press: Cambridge, MA, USA, 2020; pp. 801–812. ISBN 978-0-12-816137-1. [Google Scholar]
- Vogler, E.A.; Siedlecki, C.A. Contact Activation of Blood-Plasma Coagulation. Biomaterials 2009, 30, 1857–1869. [Google Scholar] [CrossRef]
- Liu, Y.; Zhang, Y.; Yao, W.; Chen, P.; Cao, Y.; Shan, M.; Yu, S.; Zhang, L.; Bao, B.; Cheng, F.-F. Recent Advances in Topical Hemostatic Materials. ACS Appl. Bio Mater. 2024, 7, 1362–1380. [Google Scholar] [CrossRef]
- Qin, H.; Sun, C.; He, C.; Wang, D.; Cheng, C.; Nie, S.; Sun, S.; Zhao, C. High Efficient Protocol for the Modification of Polyethersulfone Membranes with Anticoagulant and Antifouling Properties via in Situ Cross-Linked Copolymerization. J. Membr. Sci. 2014, 468, 172–183. [Google Scholar] [CrossRef]
- Liu, Y.; Li, G.; Han, Q.; Lin, H.; Li, Q.; Hua, J.; Liu, F. Anticoagulant Dialyzer with Enhanced Ca2+ Chelation and Hydrophilicity for Heparin Free Hemodialysis. J. Membr. Sci. 2020, 604, 118082. [Google Scholar] [CrossRef]
- Silver, B.J. Prolongation of Both PT and APTT. In The Coagulation Consult: A Case-Based Guide; Lichtin, A., Bartholomew, J.R., Eds.; Springer: New York, NY, USA, 2014; ISBN 978-1-4614-9560-4. [Google Scholar]
- Yang, R.; Zubair, M.; Moosavi, L. Prothrombin Time. In StatPearls; StatPearls Publishing: Treasure Island, FL, USA, 2024. [Google Scholar]
- Kim, Y.J.; Kang, I.-K.; Huh, M.W.; Yoon, S.-C. Surface Characterization and in Vitro Blood Compatibility of Poly(Ethylene Terephthalate) Immobilized with Insulin and/or Heparin Using Plasma Glow Discharge. Biomaterials 2000, 21, 121–130. [Google Scholar] [CrossRef]
- Kang, I.-K.; Kwon, O.H.; Kim, M.K.; Lee, Y.M.; Sung, Y.K. In Vitro Blood Compatibility of Functional Group-Grafted and Heparin-Immobilized Polyurethanes Prepared by Plasma Glow Discharge. Biomaterials 1997, 18, 1099–1107. [Google Scholar] [CrossRef]

| Parameter | |
|---|---|
| Surface mass | 125 (±5) g/m2—determined in accordance with the standard ISO 3801:1977 [113], Textiles. Woven fabrics. Determination of mass per unit length and mass per unit area. International Organization for Standardization: Geneva, Switzerland, 1977. |
| Textile material structure | Plain weave fabric. |
| The pH of the aqueous extract | 7.5 (±0.5)—determined in accordance with the method described in the standard ISO 3071:2020 [114], Textiles. Determination of the pH of aqueous extracts. International Organization for Standardization: Geneva, Switzerland, 2020. |
| The residue after dissolution in methane dichloride | 0.5 (±0.1)%—determined in accordance with the method described in the standard ISO 3074:2014 [115], Wool. Determination of dichloromethane-soluble matter in combed sliver. International Organization for Standardization: Geneva, Switzerland, 2014. |
| Thickness | 0.40 (±0.5) mm—determined in accordance with the method described in the standard ISO 5084:1996 [116], Textiles. Determination of thickness of textiles and textile products. International Organization for Standardization: Geneva, Switzerland, 1996. |
| Method | Magnetron Sputtering |
|---|---|
| Equipment | DC magnetron sputtering system by P.P.H. Jolex s.c. (Czestochowa, Poland) |
| Target | Copper target of 99.99% purity from Testbourne Ltd. (Basingstoke, UK) |
| Distance between the target and substrate | 15 cm |
| Deposition time | 5, 10, and 15 min |
| Working atmosphere | Argon |
| Working pressure | 2.4 × 10−3 mbar |
| Power discharge | 0.5 kW |
| Power density | 0.7 W/cm2 |
| AA Abbr. (a,b/) | a/ | Trp | His, Met | Ala, Ile, Lys, Phe, Tyr | Pro, Thr, Val | Gly | Asp c/, Leu, Ser | Arg, Cys d/ | Glu e/ |
|---|---|---|---|---|---|---|---|---|---|
| b/ | W | H, M | A, I, K, F, Y | P, T, V | G | D, L, S | C, R | E | |
| AA cont. [%] | 0–0.5 f/ | 0.6–0.9 | 3.5–5 | 5.8–6.5 | 4–8 | 7–8 | 7–10 | 13–16 | |
| Sample | Sp.T. a/ (min.) | Copper Bulk Concentration | Sample Name e/ WO-Cu(SpT) (MBC) | Copper Bulk Concentration after Washing | ||
|---|---|---|---|---|---|---|
| (mg/kg) b,c/ | MBC d/ (mol/kg) | (mg/kg) b,c/ | MBC d/ (mol/kg) | |||
| WO | - | - | - | WO | - | - |
| WO-Cu(5) | 5 | 3510 | 0.055 | WO-Cu(5)(0.06) | 2990 | 0.05 |
| WO-Cu(10) | 10 | 9020 | 0.14 | WO-Cu(10)(0.14) | 7960 | 0.13 |
| WO-Cu(15) | 15 | 24,270 | 0.38 | WO-Cu(15)(0.38) | 20,820 | 0.33 |
| Sample Name | Element Symbol | Element Name | Atomic Conc. (%) | Weight Conc. (%) |
|---|---|---|---|---|
| WO | C | Carbon | 44.583 | 39.000 |
| N | Nitrogen | 35.083 | 35.800 | |
| O | Oxygen | 19.049 | 22.200 | |
| S | Sulfur | 1.284 | 3.000 | |
| Cu | ||||
| WO-Cu(5)(0.06) | C | Carbon | 44.496 | 32.368 |
| N | Nitrogen | 26.842 | 22.777 | |
| O | Oxygen | 21.029 | 20.380 | |
| S | Sulfur | 2.571 | 4.995 | |
| Cu | Copper | 5.062 | 19.481 | |
| WO-Cu(10)(0.14) | C | Carbon | 53.169 | 36.300 |
| N | Nitrogen | 13.937 | 11.100 | |
| O | Oxygen | 22.758 | 20.700 | |
| S | Sulfur | 2.633 | 4.800 | |
| Cu | Copper | 7.503 | 27.100 | |
| WO-Cu(15)(0.38) | C | Carbon | 37.122 | 18.382 |
| N | Nitrogen | 22.829 | 13.187 | |
| O | Oxygen | 17.264 | 11.389 | |
| S | Sulfur | 2.040 | 2.697 | |
| Cu | Copper | 20.745 | 54.346 |
| Sample Name | Specific Surface Area (SSA) | Total Pore Volume (TPV) |
|---|---|---|
| m2/g | cm3/g | |
| WO | 0.2653 | 7.527 × 10−4 |
| WO-Cu(5)(0.06) | 0.1929 | 7.394 × 10−4 |
| WO-Cu(10)(0.14) | 0.1854 | 7.254 × 10−4 |
| WO-Cu(15)(0.38) | 0.1783 | 7.103 × 10−4 |
| POLYM-Cu(MBc) Material | Average Inhibition Zone (mm) | LIT. | |||
|---|---|---|---|---|---|
| Bacteria | Fungi | ||||
| E. coli | S. aureus. | C. globosum | A. niger | ||
| WO | 0 a/ | [111] | |||
| WO | 0 | 0 | 0 | This work b/ | |
| WO-Cu(0.06) | 1 | 1 | 1 | ||
| WO-Cu(0.14) | 1 | 1 | 1 | ||
| WO-Cu(0.38) | 3 | 2 | 1 | ||
| PET | 0 | 0 | 0 | [27] | |
| PET-Cu(0.11) | 1 | 1 | 3 | ||
| PET-Cu(0.22) | 2 | 1 | 3 | ||
| PLA | 0 | 0 | 0 | [28] | |
| PLA-Cu(0.16) | 2 | 1 | 1 | ||
| PLA-Cu(0.43) | 2 | 1 | 3 | ||
| PLA | 0 | 0 | 0 | 0 | [29] |
| PLA-ALG | 0 | 0 | 0 | 0 | |
| PLA-ALG-Cu(+2)(0.21) | 3 | 2 | 3 | 3 | |
| PLA-ALG-Cu(+2)(1.16) | 3 | 4 | 3 | 3 | |
| CuNPS Synth. a–i/ | Pathogens | Ref. | |||||||
|---|---|---|---|---|---|---|---|---|---|
| E. coli | S. aureus | B. subtilis | C. albicans | ||||||
| ZOI | Conc./Amount | ZOI | Conc./Amount | ZOI | Conc./Amount | ZOI | Conc./Amount | ||
| CuSO4 → CuNPS a/ | 11 | 25 μg/mL | 9 | 25 μg/mL | [185] | ||||
| Cu(OAc)2 → CuNPS b/ | 10 | 25 μg/mL | 10 | 25 μg/mL | [184] | ||||
| 23 | 100 μg/mL | ||||||||
| Cu(OAc)2 → CuNPS c/ | 2.6 | 0.21 mg/cm2 | 5.6 | 0.21 mg/cm2 | 2.8 | 0.21 mg/cm2 | 0 | 0.21 mg/cm2 | [186] |
| Cu(Succ.)2 → CuNPS d/ | 14 | 70 μL | 10 | 70 μL | [187] | ||||
| Cu(Succ.)2 | 30 | 70 μL | 34 | 70 μL | |||||
| Cu(OAc)2 → CuNPS e/ | 25 | 50 μL | 21 | 50 μL | 23 | 50 μL | [188] | ||
| WO→ | |||||||||
| CuSO4 → CuO NPS f/ | 4 | 0.28 M | 4.2 | 0.28 | [189] | ||||
| 5 | 0.56 M | 5.5 | 0.56 M | ||||||
| CuCl2 → CuO NPS g/ | 26 | 50 μL | 21 | 50 μL | 23 | 50 μL | [190] | ||
| WO → WO-CuSO4 → WO-CuNPS h,i/ + WO-Cu2O NPS h,i/ | 21 | 50 μL | [191] | ||||||
| 18 | 50 μL | ||||||||
Disclaimer/Publisher’s Note: The statements, opinions and data contained in all publications are solely those of the individual author(s) and contributor(s) and not of MDPI and/or the editor(s). MDPI and/or the editor(s) disclaim responsibility for any injury to people or property resulting from any ideas, methods, instructions or products referred to in the content. |
© 2024 by the authors. Licensee MDPI, Basel, Switzerland. This article is an open access article distributed under the terms and conditions of the Creative Commons Attribution (CC BY) license (https://creativecommons.org/licenses/by/4.0/).
Share and Cite
Mrozińska, Z.; Kaczmarek, A.; Świerczyńska, M.; Juszczak, M.; Kudzin, M.H. Biochemical Behavior, Influence on Cell DNA Condition, and Microbiological Properties of Wool and Wool–Copper Materials. Materials 2024, 17, 2878. https://doi.org/10.3390/ma17122878
Mrozińska Z, Kaczmarek A, Świerczyńska M, Juszczak M, Kudzin MH. Biochemical Behavior, Influence on Cell DNA Condition, and Microbiological Properties of Wool and Wool–Copper Materials. Materials. 2024; 17(12):2878. https://doi.org/10.3390/ma17122878
Chicago/Turabian StyleMrozińska, Zdzisława, Anna Kaczmarek, Małgorzata Świerczyńska, Michał Juszczak, and Marcin H. Kudzin. 2024. "Biochemical Behavior, Influence on Cell DNA Condition, and Microbiological Properties of Wool and Wool–Copper Materials" Materials 17, no. 12: 2878. https://doi.org/10.3390/ma17122878
APA StyleMrozińska, Z., Kaczmarek, A., Świerczyńska, M., Juszczak, M., & Kudzin, M. H. (2024). Biochemical Behavior, Influence on Cell DNA Condition, and Microbiological Properties of Wool and Wool–Copper Materials. Materials, 17(12), 2878. https://doi.org/10.3390/ma17122878

